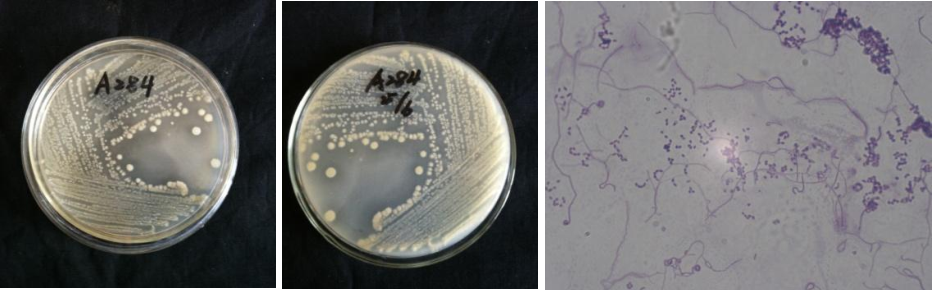

Loading...
| StrainNO | A284 |
| Classification | Actinomyces |
| 16s rDNA sequence | GACGAACGCTGGCGGCGTGCTTAACACATGCAAGTCGAACGGGATCCTTATCCGCTTGCGGGTTTGGTGAGAGTGGCGAACGGGT GAGTAACACGTGAGTAACCTGCCCCCTTCTTTGGGATAACTGCCGGAAACGGTGGCTAATACTGGATATTCAGCACTGGTCGCAT GGTTGGTGTTGGAAAGGTTTTTCTGGTGGGGGATGGGCTCGCGGCCTATCAGCTTGTTGGTGGGGTGATGGCCTACCAAGGCTTT GACGGGTAGCCGGCCTGAGAGGGTGACCGGCCACACTGGGACTGAGACACGGCCCAGACTCCTACGGGAGGCAGCAGTGGGGAAT ATTGCACAATGGGGGAAACCCTGATGCAGCGACGCCGCGTGAGGGATGACGGCCTTCGGGTTGTAAACCTCTTTCAGTAGGGAAG AATTTAGACGGTACCTGCAGAAGAAGCGCCGGCTAACTACGTGCCAGCAGCCGCGGTAATACGTAGGGCGCAAGCGTTGTCCGGA ATTATTGGGCGTAAAGAGCTCGTAGGCGGCTTGTCGCGTCTGTCGTGAAAACCTGCAGCTTAACTGTGGGCTTGCGGTGGGTACG GGCTGGCTTGAGTGCAGTAGGGGAGACTGGAATTCCTGGTGTAGCGGTGGAATGCGCAGATATCAGGAGGAACACCGGTGGCGAA GGCGGGTCTCTGGGCTGTTACTGACGCTGAGGAGCGAAAGCATGGGGAGCGAACAGGATTAGATACCCTGGTAGTCCATGCCGTA AACGTTGGGCACTAGGTGTGGGGACCAGTTCCATGGTTTCTGTGCCGTAGCTAACGCATTAAGTGCCCCGCCTGGGGAGTACGGC CGCAAGGCTAAAACTCAAAGGAATTGACGGGGGCCCGCACAAGCGGCGGAGCATGCGGATTAATTCGATGCAACGCGAAGAACCT TACCAAGGCTTGACATACACCGGAATGCTGCAGAGATGTGGCAGCCTTTGGGCTGGTGTACAGGTGGTGCATGGTTGTCGTCAGC TCGTGTCGTGAGATGTTGGGTTAAGTCCCGCAACGAGCGCAACCCTTGTCTCATGTTGCCAGCACGTGATGGTGGGGACTCATGA GAGACTGCCGGGGTTAACTCGGAGGAAGGTGGGGATGACGTCAAATCATCATGCCCCTTATGTCTTGGGCTTCACGCATGCTACA ATGGCCGGTACAGTGGGTTGCGATCTCGTGAGGGGGAGCTAATCCTTGAAAGCCGGTCTCAGTTCGGATTGGGGTCTGCAACTCG ACCCCATGAAGTCGGAGTCGCTAGTAATCGCAGATCAGCAACGCTGCGGTGAATACGTTCTCGGGCCTTGTACACACCGCCCGTC ACGTCACGAAAGTTGGTAACACCCGAAGCTCATGGCCTAACCCTTTGGGGGGGAGTGGTCGAAGGTGGGACTGGCGATTGGGACG AAGTCGTAACAAGGTAGCCGTACCGGAA |
| Strain Morphology Photos | |
| Morphological Description | The morphology of strain:hyphae branch;The septum does not break;the spore filaments are curved or helical;the spore is large;long round or elliptic;Spore pile powdery white;back bamboo shoot skin bro |